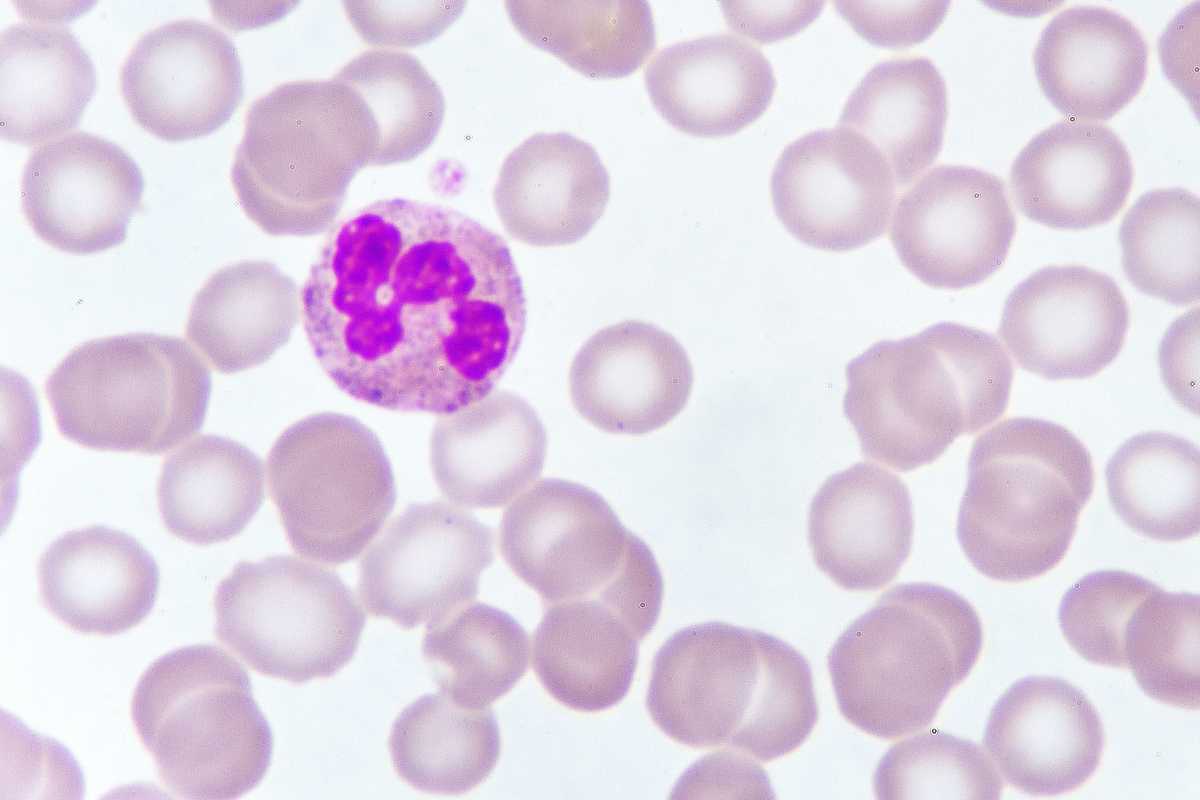
Sarà rimborsata la super cura antitumore

Arriva anche in Italia, a un anno giusto dall’approvazione in Europa, la prima terapia antitumorale con cellule Car-T (Chimeric antigen receptor T-cell). Ieri, l’Agenzia italiana del farmaco (Aifa) ha dato il via libera alla rimborsabilità, e quindi alla disponibilità nel nostro Paese, per tisagenlecleucel (nome commerciale Kymriah). Tra le più costose al mondo, la cura potrà essere utilizzata presso i centri specialistici, selezionati dalle Regioni, per pazienti adulti con tumori del sangue. In particolare il linfoma diffuso a grandi cellule B e linfomi primitivi del mediastino resistenti alle altre terapie, o nei quali la malattia sia ricomparsa dopo una risposta ai trattamenti standard, ma anche per pazienti fino a 25 anni di età con leucemia linfoblastica acuta a cellule B. Si tratta di una vera rivoluzione in campo terapeutico perché permette di riprogrammare geneticamente le cellule del paziente (i linfociti T appunto), armandole di un sensore specifico (Car) che le rende capaci, una volta reinfuse, di riconoscere e distruggere solo le cellule tumorali.
Fra tutti i pazienti eleggibili alla terapia, «la percentuale di guarigione è intorno al 35-40% per i linfomi e del 45-50% per le leucemie», spiega a La Verità Franco Locatelli, tra i massimi esperti in materia e direttore del dipartimento di oncoematologia pediatrica, terapia cellulare e genica del Bambino Gesù di Roma. Sicuramente innovativo il modello di rimborso basato sull’efficacia della cura, messo a punto tra Aifa e Azienda per una terapia che in America costa intorno ai 400.000 euro, ma che può raggiungere complessivamente, tra ricoveri e altre voci, il milione di euro a paziente. «Si passa dal classico modello del rimborso a trattamento», spiega Locatelli, «al modello innovativo del rimborso in base al risultato ottenuto (payment by result )». Si stima che i costi per il Sistema sanitario siano intorno a 300.000 euro a trattamento che, tendenzialmente, è singolo. Il modello quindi verosimilmente prevede «una quota rimborsata subito al momento dell’infusione e, se il risultato si ottiene e persiste, ci saranno trance successive», ipotizza il professore. Il Sistema sanitario dovrebbe attingere al Fondo dei farmaci innovativi oncologici (circa 500 milioni di euro/anno). Attualmente Kymriah è rimborsato anche nel Regno Unito per un prezzo che è di circa 312.000 euro, ma all’orizzonte c’è già un nuovo trattamento Car-T, già approvato sia all’Agenzia del farmaco americana (Fda) che europea (Ema). Si tratta di axicabtagene ciloleucel (nome commerciale YesCarta) per i linfomi a grandi cellule B e il linfoma primitivo del mediastino a grandi cellule B che costa sui 300.000 euro. Insomma, si sta aprendo un mercato molto promettente.
Di straordinario dentro a una sacca di queste terapie antitumorali ci sono cellule immunitarie (linfociti T) e non anticorpi (proteine). «Si tratta di un salto di qualità», continua il professore, «perché l’efficacia dell’anticorpo dipende dal tempo in cui resta in circolo, che è molto inferiore rispetto a quello delle cellule, come i T linfociti». In Italia, il primo paziente a beneficiare della terapia Cart-T è stato, a gennaio 2018, un bambino di quattro anni con leucemia linfoblastica acuta a cellule B, il tipo più frequente di tumore dell’età pediatrica (circa 400 nuovi casi ogni anno in Italia). Aveva già avuto due ricadute, ma all’Ospedale Bambino Gesù di Roma, la terapia del gruppo guidato da Locatelli ha portato alla remissione della malattia. A differenza di quella approvata ieri da Aifa, la prima Car-T italiana prevede anche l’inserimento di una sorta di gene «suicida» che, in caso di eventi avversi gravi, si attiva e bloccare l’azione dei linfociti modificati. «Proprio la potenza della cura», continua il medico, «espone il paziente a effetti collaterali anche gravi che possono richiedere il ricovero in terapia intensiva». Non a caso quindi le istituzioni prevedono, rispetto a quelli già esistenti, di arrivare a una ventina di centri regionali attrezzati di riferimento. A beneficiare di questa nuova terapia, in Italia, saranno ogni anno circa 3-400 pazienti con linfoma resistente a cui vanno aggiunti i circa 40 bambini e i giovani con leucemia linfoblastica acuta resistente.
Molte sono le speranze alimentate dai risultati degli studi in corso con la terapia Car-T non solo in questi tumori del sangue resistenti, per cui si stanno sperimentando impieghi in fase più precoce della malattia. Sempre al Bambino Gesù è in corso uno studio, con risultati molto positivi, per la cura del neuroblastoma (tumore cerebrale infantile molto diffuso). La terapia Car-T è studiata anche per il mieloma multiplo (4.000 nuovi casi all’anno) e in costante aumento per via dell’invecchiamento della popolazione. Una sfida sono i tumori solidi, che hanno caratteristiche biologiche che li rendono più resistente al trattamento con cellule Car-T. I primi risultati si sono avuti su pazienti con tumori cerebrali, sarcomi e mesotelioma, ma rimangono ancora ostacoli da superare. A mantenere accesa la speranza sono i risultati positivi nel trattamento del carcinoma della prostata in fase avanzata. Sta iniziando una nuova era in oncologia, sempre che i fondi sanitari reggano.






